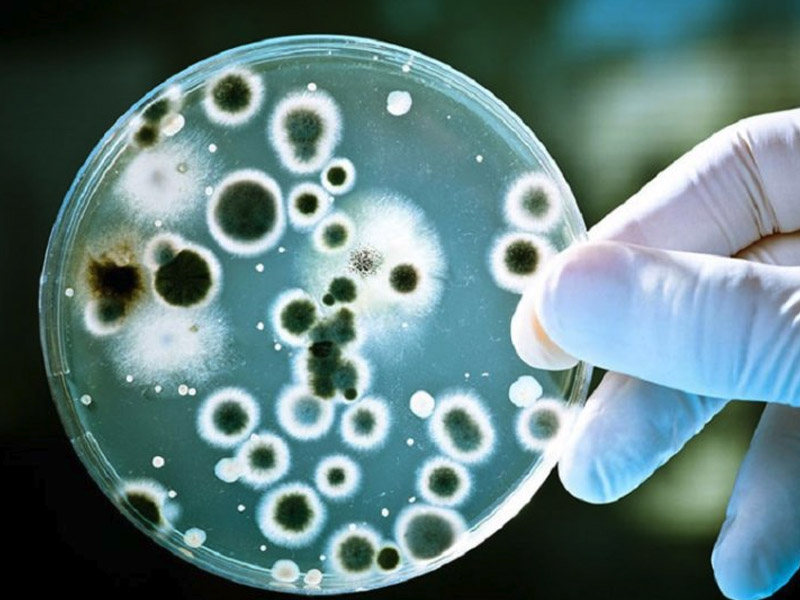

Fue en 2009 cuando los científicos identificaron por primera vez al hongo Candida auris, que había infectado a una paciente en Japón. Nueve años después, este hongo ya ha activado una alerta mundial tanto por su rápida propagación como por su resistencia a los medicamentos antimicóticos.
Hasta el 2019, Estados Unidos, Canadá, Venezuela, Reino Unido, Alemania, Francia, España, Pakistán, Japón, India, y varios países del continente africano, entre ellos Sudáfrica, reportaron infecciones por Candida auris.
Generalmente, la trasmisión sucede a través de las manos del personal de salud y del entorno que rodea al paciente. Cuando este ingresa en el torrente sanguíneo, puede provocar infecciones y enfermedades peligrosas que afectan el corazón y el cerebro.
Los síntomas se pueden confundir con los de otras infecciones, lo cual agrava su tratamiento temprano. Según el CDC, la fiebre alta y los escalofríos que no mejoran con un curso de antibióticos podrían ser señal de un caso de Candida auris. A menudo, las personas afectadas ven agravadas otras patologías previas. Las personas con un sistema de salud debilitado están más en riesgo.
De acuerdo con The New York Times, este hongo suele ser resistente a las medicinas que se usan para tratar este tipo de infecciones. Los Centros para el Control y la Prevención de Enfermedades (CDC), más del 90 por ciento de las infecciones por Candida auris son resistentes a por lo menos uno de esos medicamentos, mientras que el 30 por ciento son resistentes a dos o más de los principales antimicóticos.
La principal dificultad de este hongo es ofrecer tratamiento, debido a que tiene resistencia innata a unas cuantas drogas antibióticas y antifúngicas que se usan habitualmente.
Por ahora, la solución más pronta es “usar mejor los antibióticos y usar mejor las medidas de control de las infecciones intrahospitalarias, por eso de alguna manera estos temas también tienen que ver con una mirada más integral sobre el ámbito de la salud”.